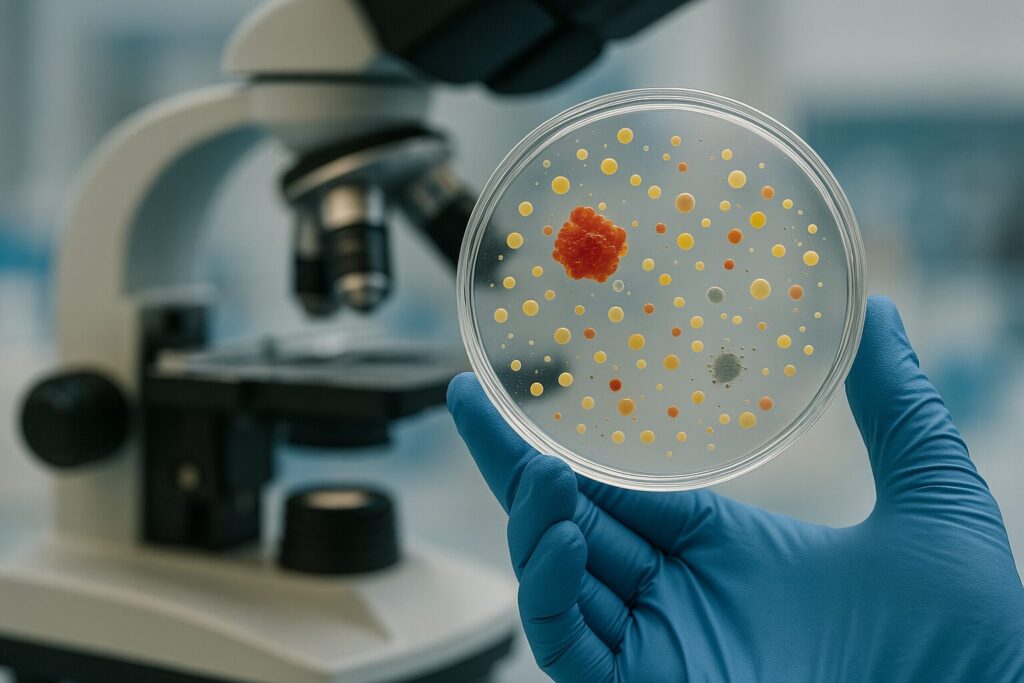
Batteri resistenti

Un team del Politecnico di Milano ha sviluppato una tecnica innovativa per controllare i batteri tramite luce, senza ricorrere a modifiche genetiche. Il progetto ERC EOS – Engineering Of bacteria to See light utilizza molecole fotosensibili che, legandosi alla superficie batterica, permettono di modificare il potenziale elettrico di membrana semplicemente con l’esposizione alla luce. Questa “optomodulazione” regola funzioni vitali come motilità, formazione di biofilm e sensibilità agli antibiotici.
Il metodo si propone come risposta alla crescente minaccia della resistenza antimicrobica. I ricercatori hanno testato la molecola fotosensibile Ziapin2 su Bacillus subtilis, dimostrando come la luce blu (470 nm) possa ridurre o mantenere l’efficacia di antibiotici come la Kanamicina e l’Ampicillina, influenzandone l’assorbimento cellulare.
Il progetto, guidato da Giuseppe Maria Paternò, ha ricevuto un finanziamento di 1,5 milioni di euro dall’ERC e punta anche alla creazione di “robot batterici” per il rilascio mirato di farmaci. I risultati sono stati pubblicati su The European Physical Journal Plus e aprono nuove prospettive per tecnologie antimicrobiche foto-guidate e biocompatibili.

Vuoi ricevere le notifiche sulle nostre notizie più importanti?
Vuoi ricevere le notifiche sulle nostre notizie più importanti?